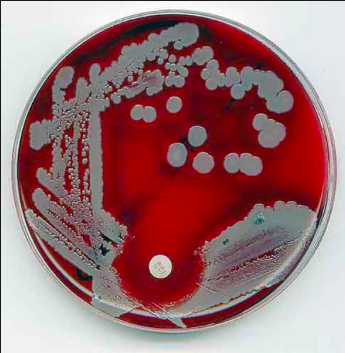

The color of micro-organisms (fungi, bacteria, algae etc…) is due to different colored substances in the cells. For example, bacteria uses a variety of chlorophyll (the green pigment in plants) and absorb light which is different wavelengths which creates natural colors of purple, pink, green, yellow, orange, and brown.
I loved the colours that I saw so I created colour palettes from some photographs of bacteri in a petri dish i found online.

The colours that are created really interest me so I picked a few images from google of bacteria and created colour palettes from each of the images.

I then used these colour palettes to create a more simplistic representation of bacteria – I based it around photographs of cultivated bacteria in Petri dishes.

This then led me to return to data visualisation as the circles reminded me of data layouts that I’ve seen used in the Guardian for example.

Bowen University research showed that the colours of the bacteria depend on the species and the culture media used (their ph level). They usually become visible as distinct colonies with each colony representing a particular bacterial cell which has undergone repeated division. Then, these cells subsequently accumulate to form a visible patch.
Most colonies of bacteria are usually white, cream or yellow in color and occasionally, some are golden yellow, peculiar red (Serratia marcescens, Oscillatoria rubescens, Shigella) brown, blue or green.

It depends on the type of Petri dish/agar used and many other factors however, for example “S. aureus appears as whitish to creamy on Nutrient agar and as golden yellow on MSA; E. coli appears as pink on McConkey, pale yellow on CLED and green metallic sheen on EMB; Salmonella and Proteus both grow as blue colonies on CLED while this same Salmonella grows as translucent/colorless colonies on Salmonella-Shigella agar. Its counterpart – Shigella produces red pigments on S-S agar. Interestingly, both Salmonella and Shigella apear as pink on XLD agar since they can’t ferment any of the sugars that are present in the media.”
This led me to look at how a background colour can change the way we see colours, so I looked at how different colours affected red. The red seems to be brighter against the black and the blue-green, it looks duller on the white and it appears almost lifeless against the orange.

